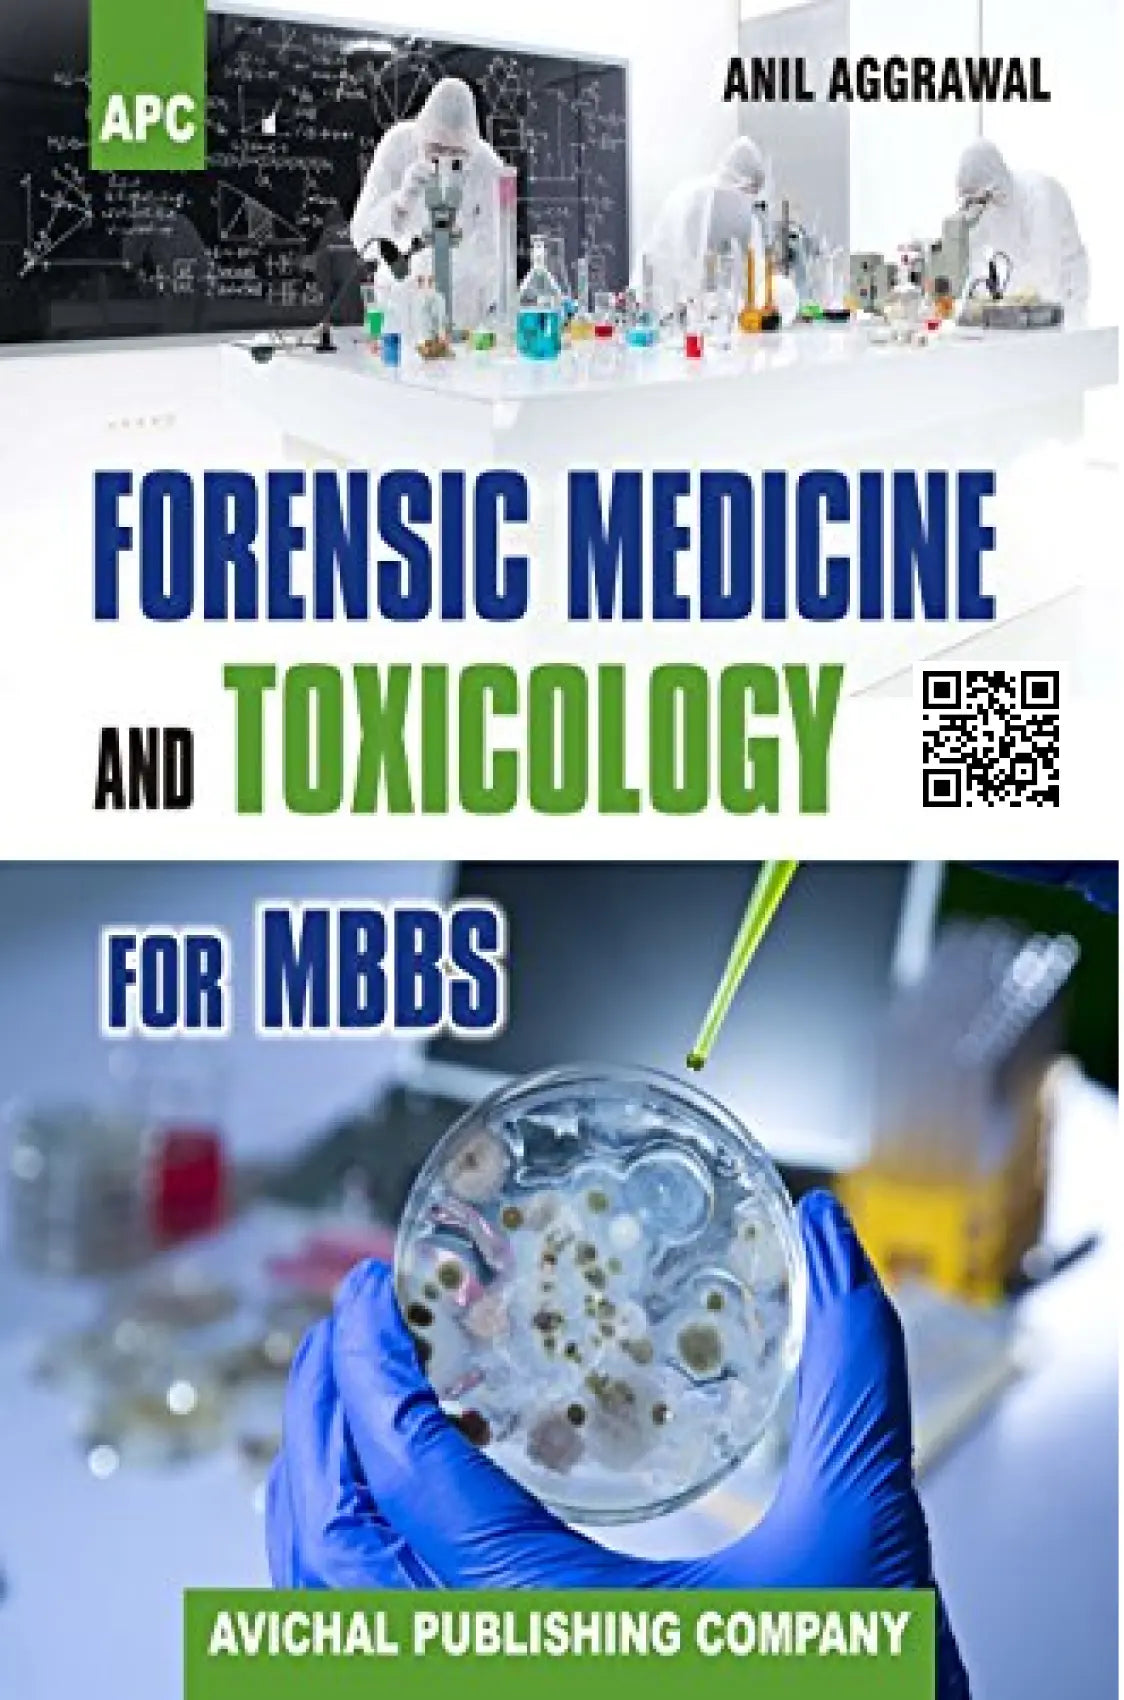

Vendor: CBS Publishers & Distributors Pvt. Ltd
Type: Medical Books
Price:
942.00
Parikh’s Textbook of Medical Jurisprudence, Forensic Medicine and Toxicology for Classrooms and Courtrooms 9ed is an up-to-date and comprehensive guide for medical students and legal professionals. Written by Subrahmanyam B.V., this text provides authoritative information on medical and forensic law, as well as toxicology. Perfect for use in classrooms or courtrooms.
Product details
Publisher : CBSPD
Author : Subrahmanyam B.V.,
Language : English
Edition : Latest by Publishers
ISBN-10 : 9354662749
ISBN-13 : 9789354662744